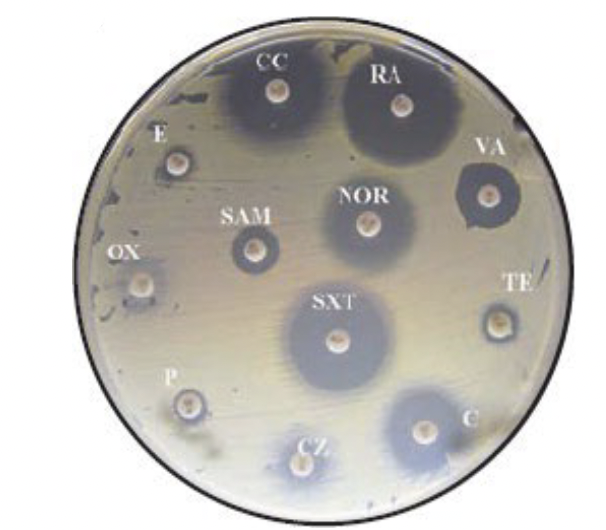
<p>a zone of clearing in a bacterial lawn around a filter disk soaked in an antimicrobial agent</p><ul><li><p>as agent diffuses out, the concentration decreases</p><ul><li><p>the larger the zone, the lower the concentration required to kill the microbe</p></li></ul></li></ul><p></p>

Second Unit MICRO xP
1/202
There's no tags or description
Looks like no tags are added yet.
Name | Mastery | Learn | Test | Matching | Spaced | Call with Kai |
|---|
No analytics yet
Send a link to your students to track their progress
203 Terms
Normal growth conditions
20-40˚ C
pH 6-8
High nurtients
0.9% salt
sea-level pressure (1 atm)
Extremophiles
Grow in extreme conditions
anything other than the “normal”
need unique adaptations to make them tolerent to extreme conditions
Cardinal conditions
the values of the minimum, maximum, and optimum growth conditions that support growth of an organism
Temperature

Psychrophiles
< 15˚ C
Mesophiles
20-45˚ C
Most microbes that we encounter
don’t die below minimum, just don’t grow
Thermophiles
45-80˚ C
Hyperthermophiles
> 80˚ C
Use of heat to control microbial growth
Mechanisms of action: proteins (enzymes) can be denatured, and membranes can be disrupted
amount of killing is proportional to both temperature and time of exposure to heat
Higher temperature and longer = increase killing

Use of heat to control microbial growth: Boiling
100˚ C = 212˚ F
kills vegetative cells and viruses but NOT bacterial endospores
Use of heat to control microbial growth: Autoclaving
121˚ C = 250˚ F
Uses steam under pressure, moist heat penetrates cells well
kills vegetative cells, viruses, AND bacterial endospores (dependent on time) (>15 min)
Use of heat to control microbial growth: Dry heat sterilization
requires long time to kill endospores
used for objects
Use of heat to control microbial growth: Pasturization
Traditional: (50-75˚ C for 30 min) - Louis Pasteur’s orginial method
Flash: (50-75˚ C for 15 sec, then rapid cooling) - used to reduce microbial numbers without altering flavor (milk, wine, beer); lengthens shelf life
UHT (ultra high temp): (135˚ C for 1-2 sec) - used to sterilize milk to enable storage at room temp
Use of cold to control microbial growth
Refrigeration
bacteria do not grow or grow slowly
Freezing
bacteria die slowly, so are still present after the food is taken out of the refrigerator
Growing cells acidify the area they are in by:
Transport
PMF
Metabolism
But too acidic or basic = bad
Internal pH – maintained at pH 5-8
pH <5 damages membrane and inactivates many enzymes → lethal
Use of pH to control microbial growth
Used in food preservation
low pH, cells cant easily adapt, dead cells
Osmolarity
= Water availability
measure of the degree of water availability - inversely related to osmolarity (measure of the solute molecules in a solution)

Limiting water availability to microbes prevents growth
water limitation may result from high osmolarity
salted foods - beef jerky, ham, bacon
sugared foods - jellies and jams
Water limitation may result from desiccation (absence of water)
bread, crackers, cheerios
Oxygen
Organisms differ in their need for oxygen
oxygen-based metabolism use oxygen as terminal electron acceptor in a process called respiration
Oxygen readily forms reactive oxygen species (ROS)
their high reactivity damages cellular components

Oxygen relationships to microorganisms: Aerobes
Cultures usually grown with vigorous shaking to give them O2

Oxygen relationships to microorganisms: Anaerobes
Do not use O2 as a terminal electron acceptor in respiration
live in O2 free environments

Oxygen Summary

Use of radiation to control microbial growth
Kills by damaging DNA (causes breaks)
is poor at penetrating many materials (glass or plastic)
used for sterilizing surfaces
Ionizing radiation
X-rays & Gamma rays
has higher energy than UV radiation so penetrates materials well produces ions when it hits biological molecules (very damaging
used for sterilizing antibiotics, surgical supplies, food, plastic supplies, etc.
Filtration (for liquids)
Physical removal of microbes - depends on pore size
For liquids:
membranes usually have pore sizes of 0.2 or 045 um to remove bacteria
do not remove viruses

Filtration (for air)
Physical removal of microbes - depends on pore size
For air:
N95 filters remove particle. Use both:
mechanical filtration: remove viruses in water droplets
electrostatic filtration: special mask fabric is charged → attracts and binds viruses)

Decontamination
reducing microbes to a relatively safe level
Type of decontamination: Disinfection
Disinfection
killing, inhibiting, or removing microbes that may cause disease
Sterilization
Complete killing or removal of all organisms
autoclaving
gas sterilization (ethylene oxide, chlorine) for items destoryed by autoclaves
Chemical antimicrobial agents
chemicals that kill or inhibit the growth of microorganisms
disinfectants
sterilants
chemotherapeutic agents (chemical agents that are used to treat disease)
Antibiotics
“anti-life”
chemicals that are produced by microbes that can kill or inhibit the growth of other microbes
include some synthetic chemicals modeled after antibiotics
Cidal agents
agents that kill microbes
(bacteriocidal)

Lytic agents
a subset of cidal agents that kill bacteria by lysing them
(bacteriolytic)

Static agents
agents that reversibly inhibit pathogen growth
Reversible: growth resumes when the antimicrobial agent is gone
(bacteriostatic)

Minimum inhibitory concentration (MIC)
the lowest concentration of a chemical that prevents growth of an organism
add the same number of microbes to each tube, add increasing concentrations of a chemical, and evaluate growth

Zone of inhibition
a zone of clearing in a bacterial lawn around a filter disk soaked in an antimicrobial agent
as agent diffuses out, the concentration decreases
the larger the zone, the lower the concentration required to kill the microbe
Selective toxicity
the ability to kill or inhibit the growth of a pathogen while damaging the host as little as possible
Spectrum of activity:
Broad spectrum - effective against many species ( if too broad can kill benificial organisms)
Narrow spectrum - effective against few or a single species (ideal if we only want to kill target)
Properties of chemotherapeutic agents
Most antibiotics were discovered as natural microbial products but have been modified to:
→ increase their toxicity to the microbes
→ decrease their toxicity to humans
→ narrow their spectrum of activity
Mode of actions of antibiotics
Knowing themode can tell us:
if an antibiotic is likely to work on a pathogen
the probability that the pathogen will become resistant to the antibitoic
Mode of action of antimicrobial drugs

Cell wall synthesis inhibitors
Inhibit enzymes that form cross links in peptidoglycan
target of the majority of antibiotics
high selective toxicity
Penicillins & Cephalosporins
Protein synthesis inhibitors
Halt protein synthesis
Generally bind to prokaryotic ribosomes
High selective toxicity
At high concentrations can inhibit mitochondria
Often bacteriostatic (once removed, ribosomes resume function)
Macrolides
Nucleic acid synthesis and transcription inhibitors
interfere with DNA or RNA production by targeting enzymes or blocking the building blocks, preventing cell growth and replication
Cell components involved in these functions are relatively similar in prokaryotes and eukaryotes
Quinolones
Cell membrane disruptors
agents that target and compromise the integrity of the cell membrane, leading to cell death or dysfunction
Membrane structure is similar in prokaryotes and eukaryotes
low selective toxicity (so — not great for us!)
Some specific targets have been found:
Dapotymcin - binds to specific lipids in the bacteria membrane, causing pore formation and depolarization
Platensimycin - inhibits fatty acid biosynthesis in bacteria
Growth factor analogs = Anti-metabolites
Chemicals that resemble growth factors but block metabolic pathways by competitively binding to metabolic enzymes
Sulfa Drugs = sulfonamides
Synthetic compounds that compete for the active site of an enzyme involved in folic acid synthesis
folic acid is required for purine and pyrimidine biosynthesis
humans do not synthesize folic acid, so are not affected by sulfa drughs
High selective toxicity!
How do microorganisms become resistant to antibiotics?
Modification of the drug target through mutation
Introduction of a resistance gene
Formation of a biofilm
Modification of the drug target through mutation
Spontaneous mutations change the targets so that it no longer binds an antibiotic

Introduction of a resistance gene, which may:
destroy the antibiotic before it gets in (enzymatic inactivation)
Beta - lactamase breaks Beta - lactam ring in penicillins)
Chemically modify the antibitoic so that it is no longer active
add phosphategroup to kanamycin and inactivate it)
Pump the antibiotic back out of the cell before it can do damage
pump out tetracycline
Formation of a biofilm
Enhances resistance by many mechanisms, such as:
slowing diffusion so antibitoic doesnt reach many cells
promoting cells generally are not damaged by antibiotics


Major cause of antibiotic resistance
Extensive use of antibiotics:
Antibiotics are used as an additive in animal feed
Antibiotics are overperscribed
Antibiotics are improperly used
Effect: many bacterial infections are becoming untreatable
Strategies to reduce the emergence of antibiotic resistance
Use high doses to kill all bacteria
Complete full antibiotic treatment program
Use a narrow spectrum antibiotic whenever possible
Develop new antibiotics
10 million times more _____ on Earth than stars in the sky
Viruses!
Ivanowski (1892)
Took sap from diseased plant, filtered it for bacteria, applied to a healthy plant = diseased plant
something smaller than bacteria that was infectious was there!
Beijerinck (1900)
This “toxin” had many properties of living organisms - could reproduce but needed a host
Called this entity a “virus” = poison or venom
More history

What is a virus?
a non-cellular particle that contains a genome
lacks independant metabolism
needs a host to reproduce
obligate intracellular parasite
Virion
A complete viral particle; the form of a virus that occurs extracellularly (outside a host cell)
Impacts viruses have on host cell
Host cell Lysis
May insert into genome and replicate with host cell
may be there for long time, then when jump out lyse host
may help host (few cases)
Virus structures
Nucleic acid: DNA or RNA
Capsid: protein coat, individual proteins are capsomers
Envelope: Bilayer membrane from host that the virus takes as it escape the host cell

Virions do not contain __________ or __________
cytoplasm or ribosomes
Accessory proteins
contained in the envelope of virus, within the caspid, or between envelope and caspid
Some help entry into, or release from, host cells
lysozyme-like enzymes (bacterial viruses)
Neuraminidases (spike proteins)
Some help transcribe or replicate the viral genome
Polymerases - particularly important for RNA viruses

Viral sizes and shapes: Rod-Shaped
Filamentous (helical) virus
capid like hallow tube
Proteins arranged in helix
resulting rod may be rigid or flexible
length is determined by genome size
filament can be inside an envelope

Viral sizes and shapes: Spherical viruses
Icosahedral virus
polyhedron
efficient approximation of a sphere
Icosahedral can be inside an envelope

Viral sizes and shapes: Complex virus
often have icosahedral head and helical tail
may also have additional structures (tail fibers & collar)

Viral genomes
May be:
DNA
single stranded (ss) DNA
Double stranded (ds) DNA
RNA
ssRNA
dsRNA
Most DNA viruses are ______. Most RNA viruses are ______.
Most DNA viruses are dsDNA.
Most RNA viruses are ssRNA.
____ most common among bacterial virues.
____ most common among plant virues.
dsDNA most common among bacterial viruses.
ssRNA most common among plant viruses.
All types represented among animal viruses.
Genome structure
DNA may be linear or circular
RNA is always linear, may be segmented
How do we grow viruses? (Cultivation of Bacteriophage)
Viruses depend on a host to replicate — so for bacteriophages, we need bacteria

Growth of bacteriophage on an agar plate: Plaques
Plaques: zone of clearing that results from cell lysis
Phage count = # plaque-forming units/ml
= #PFU/ml
= Phage titer
Use PFU because not every virion is infective

Cultivation of animal viruses
Animal organ → separate into individual cells → grow in tissue culture
Add virus → Add layer of agar → Plaques form in the monolayer of tissue
Steps to viral infection

Steps to viral infection: Attachment
Virion recognizes host cell → adsorbs to surface

Steps to viral infection: Penetration
viral genome penetrates the host cell
bacterial viruses: inject the genome and caspid remains outside
animal viruses: virion enters the host cell and genome is then released within the cell

Steps to viral infection: Replication
Viral genome and proteins are synthesized through redirection of the host cell machinery

Steps to viral infection: Assembly
Caspids are formed, and genomes are packaged in caspids to form virions

Steps to viral infection: release
Virions are released from the host; the host cell dies

Examples of bacteriophage
T4 phage → infects E. coli
lyses host cells → death
Lambda (λ) phage → infects E. coli
inserts into genome and replicates with host cell → can hide for generations then jumps out of the genome and lyses the host
Both are dsDNA viruses
Host recognition and attachment
Phage attach to Bacterial receptors: specific bacterial cell surface components
Receptors are required for infection: determine the “host specificity” of a phage

Penetration of the genome into the host cell
= injection of genome
tail tube is injected down
Lysozyme is released - degraded peptidoglycan
DNA is injected

Synthesis of viral genome and proteins
Host DNA, RNA, and protein is halted; Host DNA degraded
Host cell machinery is redirected to synthesize viral constituents
express “early genes” first (encode proteins that promote genome replication)
express “middle & late genes” second (caspid proteins, tail fibers, collar proteins)
Assembly of caspids and packaging to form virions
Caspids form with help of scaffolding proteins - hold capsid “prohead” together
Nanomotor assembles on prohead
Nanomotor uses ATP to pack DNA in (displaces scaffolding proteins)
Tails and tail fibers are attached
~200 T4 virions are assembled inside host cell

Release from the host cell
Once the host cell is full of mature virions:
a lysozyme-like enzyme helps degrade peptidoglycan
another enzyme helps break cytoplasmic membrane\
the cell lyses
One-step growth curve
Measure how long it takes to replicate and how many virions each cell releases

One-step growth curve PARTS:
Eclipse period: period during which no infective virions are released
Burst period = rise period = maturation phase
Burst size: number of virions released per bacterium
information on a given phage: how long to replicate, hoe many virions released

Latent period
= the shortest time necessary for viral reproduction

Time course of events in T4 phage infection

Virulent phage
= lytic phage
a phage that experiences only a lytic life cycle (aka cell pops open and dies)
(ex. T4 phage)
Temperate phage
= lysogenic phage
a phage that experiences lytic and lysogenic cycles (cen lyse a cell or incorporate into the genome)
(ex. lambda phage)

Lysogenic life cycle
bacteriophage infect and the genome is replicated with the host chromosome
Prophage
a phage that is intergrated into the host’s genome
many bacteria have many prophage
Lysogeny
a state in which a phage remains within a bacterial cell and reproduces as the host cell reproduces
Induction
the process of initiating phage reproduction in a lysogenic cell
What triggers induction?
Conditions that threaten host cell survival
low nutrient avaliability, DNA damage, shofts in pH/temp
phage need healthy host to multiply → stressed host bad
Most bacteriophages are _____________ phages
lysogenic (temperate)
How do bacteria defend themselves against phage?
lose the receptor required for phage adsorption
produce enzymes that break down foreign DNA (restriction enzymes)
Use an adapative immune system against current and future infections (CRISPR/Cas system)
CRISPRs
bacterial defense system against phage
DNA regions with repeated DNA sequences that are interspersed with short DNA sequences (“spacers”) acquired from infecting phages
Clustered Regularly Interspaced Short Palindromic Repeat
